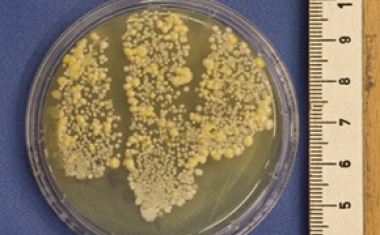
Photo

Infektionsschutzgesetz gefährdet Erfolge in der Pandemiebekämpfung
Testpflichten für Vulnerable Gruppen sind nicht ausreichend.

Testpflichten für Vulnerable Gruppen sind nicht ausreichend.

Das im Deutschen Bundestag beschlossene Bevölkerungsschutzgesetz (3. Gesetz zum Schutz der Bevölkerung bei einer epidemischen Lage von nationaler Tragweite) setzt zur Bekämpfung der COVID-19-Pandemie auf möglichst einheitliche Maßnahmen bundesweit, statt auf die bisherigen länderspezifischen Regelungen.